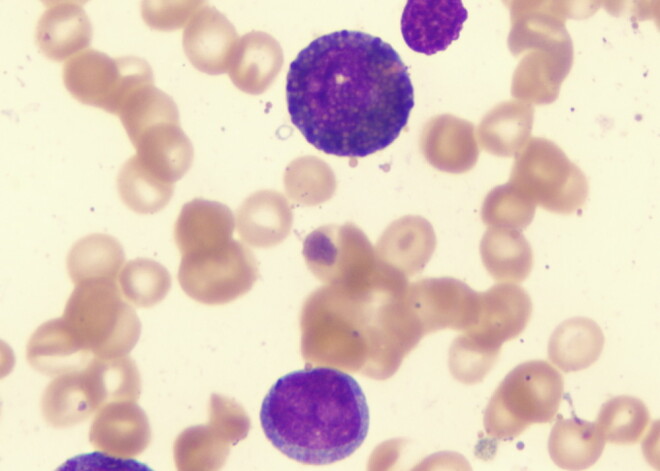

Ученые назвали новый способ уничтожения раковых клеток
При введении специального вещества в организм пациента можно вызвать так называемую «митатическую катастрофу». Отметим, что значительная часть всех злокачественных опухолей возникает из-за поломки в гене р53, который отвечает за синтез белка и следит за целостностью генетической информации.
В случае «перерождения» клетки ген р53 может запустить функцию самоуничтожения, однако биологический механизм срабатывает только при серьезных повреждениях ДНК. Биологи сообщили и об альтернативном способе «самоуничтожения» клеток, назвав его «митотической катастрофой». Данный процесс приводит к резкому увеличению размеров клетки, появлению «лишних» ядер и ее гибели при делении.
По словам онкологов, так называемая «митотическая катастрофа» представляет собой сложную систему, предназначенную для защиты организма при повреждении ДНК. Данный механизм убивает клетки еще до того, как они могут «переродиться» в раковые новообразования.
Для запуска «митотической катастрофы» в организме человека с онкозаболеванием, необходимо прекратить доступ кислорода к митохондриям. В настоящее время российские биологи проверяют несколько соединений, способных вызывать подобную реакцию в раковых клетках, остановив при этом массовую гибель их здоровых соседей, передает «РИА новости».
По словам экспертов, к основным факторам, повышающим риск появления онкозаболевания относятся: курение, лишний вес (ожирение), алкоголь, инфекции, загрязнение атмосферы, воздействие радиации, плохая наследственность.
Так, курение может вызвать рак трахеи, бронхов, легких. Появление лишнего веса способствует развитию рака пищевода, кишечника. Пристрастите к алкоголю может привести к раку глотки, полости рта, гортани, пищевода. Инфекции - рак печени, рак шейки матки. При загрязненной атмосфере может развиться рак легких. Воздействии радиации - лейкемия.